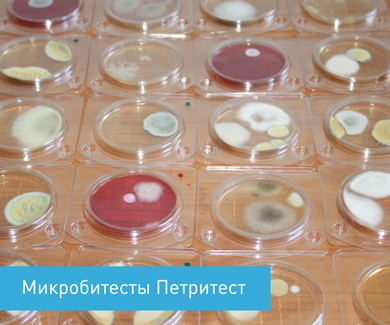
image

БГКП. К бактериям группы кишечных палочек (колиформных) относят роды Escherichia (типичный представитель E. coli), Citrobacter (типичный представитель C. colicitrovorum), Enterobacter (типичный представитель E. aerogenes), которые объединены в одно семейство Enterobacteriaceae благодаря общности свойств.
Общая хар-ка БГКП: — палочки грамм-отрицательные, короткие; — не спорообразующие; — на среде Энда дают красные колонии с металлическим блеском — E.coli, красные – энтеробактерии, розовые – цитробактерии, б/цв – лактозо – отрицательные.Биохимические свойства. Большинство бактерий группы кишечных палочек (БГКП) не разжижают желатина, свертывают молоко, расщепляют пептоны с образованием аминов, аммиака, сероводорода, обладают высокой ферментативной активностью в отношении лактозы, глюкозы и других сахаров, а также спиртов. Не обладают оксидазной активностью. Устойчивость. Бактерии группы кишечных палочек обезвреживаются обычными методами пастеризации (65-75°С). При 60°С кишечная палочка погибает через 15 минут. 1% раствор фенола вызывает гибель микроба через 5-15 минут.Санитарно-показательное значение. Бактерии рода Escherichia– постоян. обитатели кишечника чел и животн, и обнаружение их в воде и ПП свидетельств о свежем фекальном загрязнении. Бактерии родов Citrobacter и Enterobacter могут находиться повсюду: в почве, на растениях, реже в кишечнике. Считают, что они предст собой результат изменен ишерихий после пребывания их во внешней среде и поэтому являются показателями более давнего фекального загрязнения. Значение БГКП:
— в сыром молоке указывает — на на эпидемиологическую опасность
— через несколько часов при 8-10 о С — о нарушении условий хранения и реализации, транспортиров.
— появл. БГКП после пастеризации расценивают как 2-ое загрязнение
— наличие БГКП в готовой продукции указывает на — плохую мойку и дезинфекцию оборудования.
Род Salmonella. Сальмонеллезы относятся к числу наиболее распространенных токсикоинфекций. Обнаруж сальмонелл всегда свидетельствует о фекальном загрязнении. Сальмонеллы устойчивы к высоким концентрациям поваренной соли (особенно в средах, содержащих белок) и высушиванию. Сохраняют свою жизнеспособность в комнатной пыли, в различных почвах (97 мес.), в воде открытых водоемов (до 45 дн). Находясь в ПП, особенно в мясных, сальмонеллы очень устойчивы к тепловой обработке. Соление и копчение мяса оказывают слабое воздействие на сальмонелл. При размножении сальмонелл в молоке его внешний вид и вкус не изменяются, пастеризация молока в течение 30 мин при 85ºС в производственных условиях способствует полному уничтожению этих бактерий. Человек заражается сальмонеллами в результ употребл мяса и мясопродуктов. Молоко и молочные продукты гораздо реже явл причиной пищевых отравлений. Инфицирование молока главным образом происходит через загрязненную посуду, доильные аппараты, руки доильщиц и др. Возбудители сальмонеллезов могут попасть в ПП, изготовленные из растительного сырья (салаты и соусы столовые) не только в процессе производства, но и с пищевыми ингредиентами, в частности с сухими овощными приправами и специями.
| Микробиол-й пок-ль | Санитарно-гигиенич-е значение | Колич-й критерий, | Характеристика |
| БГКП | Для хар-ки санитарно-эпидем. состояния пищевых продуктов и условий их изготовления | Более 10 3 КОЕ/г(см 3 ) Наличие E. coli | Низкое санит. состояние пищ-го прод-та и усл-й его изгот. Свежее фекальное загрязнение |
| Сальмонеллы | -//-и для хар-ки безопасности для потребителя | обнаружение в 25г продукта | Низкое санит. состояние пищ-го прод-та и усл-й его изгот., опасность продуктадля чел |
Идентификация БГКП:
● Посев на среду обогащения — Кесслер, одновременная идентификация по газообразов.: есть газообразование — возможно БКГП, нет газообразования — нет БГКП
● Идентификация БГКП на среде Эндо: Из газ(+) пробирок отбирают по 1 мл и сеют на тв.среду Эндо, идентифицируют колонии БГКП по цвету, проводят дифференциацию по родам в зависимости от цвета колоний: Если есть красные, розовые и бледно-розовые культуры — значит присутствуют БГКП, если нет колоний – нет БГКП. Если есть колонии, но бесцветные — подозрение на патогены. Далее по цвету идентифицируют роды БГКП: 1) красные — с металлич. оттенк. – эшерихия 2) розовые – энтеробактер 3) бледно-розовые — со слизью – клебсиела 4) бледно-розовые — цитробактер, церрации 5) бесцветные (лактозо (-)) — протей 6) прозрачные мелкие – патогенны
● Идентификация на среде Козера: выращивание на среде с глюкозой/лимонной кислотой, Т=43°С,24ч. М/о цитрат(+) меняют цвет красителя с зеленого на васильковый. М/о цитрат(-) не меняют цвет.
Определяют по количеству положительных проб в 3 пробирках.
Сальмонеллы – патогенны, анализируют в 25 г продукта, их там не должно быть. Служат индикатором патогенов.
Выявление сальмонелл проводится в 4 этапа
1) первичный (прямой) посев — Посев на среду Энда и Плоскирава на сутки и Т=37 0 С. На ср. Энда – прозрачные колонии,
2) обогащение (посев на жидкие селективные среды, термостатирование)
3) посев со среды обогащения осущ после обогащения на плотные диагностические среды, термостатирование — на ср. Плоскирава- прозрачные,но более мелкие чем на среде Эндо
4) подтверждение путем установления ферментативных и серологических свойств сальмонелл
Общая характеристика семейства Enterobacteriacae.
Острые бак.киш. инфекции- диареи- относятся к числу наиб. распространенных болезней.Семейство Enterobacteriacae объединяет бактерии, которым присущи следующие признаки:
1)единство морфологии- короткие, не образующие спор палочки с закругленными концами, подвижны(перитрихи) или неподвижные, не обр. или обр. капсулу.
3) ферментируют глюкозу и ряд др. углеводов с обр. кислоты и газа или только кислоты
4)как правило отсутствуют протеолитические свойства
5)фак.анаэробы или аэробы
6)хорошо растут на обычных пит.средах
7) обитают в киш.тракте и дых.путях
8)фекально-оральный(иногда воз-кап) путь заражения
9) нет цитохромоксидазы
11)восстанавливают нитраты и нитриты
13) сумма Г+Ц в ДНК 39-59 мол%
Признаки, по которым дифференцируют роды семейства Enterobacteriacae.
В основном биохимические.Каждый род имеет свои бх свойства, а внутри рода имеются виды,определяемые также на основе бх свойств! Используют следующие признаки: ферментация глюкозы, маннита, лактозы, сахарозы, рамнозы, образование H2S, индола, рост на голодной среде с цитратом натрия, гидролиз мочевины, декарбоксилирование орнитина, дегидрирование аргинина, дезаминирование фенилаланина, подвижность, обр.ацетона при ферментации глюкозы(р-я Фогеса-Проскауэра), проба с метиловым красным(MR) и др.Большое значение для классиф. внутри родов имеет изуение АГ строения(О и Н и К антигены).
БХ свойства — способность микроорганизмов потреблять различные вва(белки, УВ и др) с образованием хар-ных конечных продуктов или наличие у них различных ферментов!
Биологическое, мед. и сан. значение киш. палочки(я напишу чтобы было, немного, всё равно вряд ли спросят)
Санитарно-показательное значение отдельных родов бактерий группы кишечных палочек неодинаково. Обнаружение бактерий рода Escherichia в пищевых продуктах, воде, почве, на оборудовании свидетельствует о свежем фекальном загрязнении, что имеет большое санитарное и эпидемиологическое значение. Считают, что бактерии родов Citrobacter и Enterobacter являются показателями более давнего (несколько недель) фекального загрязнения и поэтому они имеют меньшее санитарно-показательное значение по сравнению с бактериями рода Escherichia. При длительном применении антибиотиков в кишечнике человека также обнаруживают различные варианты кишечной палочки. Особый интерес представляют лактозоотрицателъные варианты кишечной палочки. Это измененные эшерихии, утратившие способность сбраживать лактозу. Они выделяются при кишечных инфекциях человека (брюшном тифе, дизентерии и др.) в период выздоровления. Наибольшее санитарно-показательное значение имеют кишечные палочки, не растущие на среде Козера (цитратная среда) и ферментирующие углеводы при 43-45°С (E. coli).Они являются показателем свежего фекального загрязнения.
Культуральные и бх свва киш.палочки.
· Видовое название возбудителя и его систематическое положение.
E.coli.Род Escherichiaотносится к семействуEnterobacteriaceae.
· Морфологические свойства.
Имеют перитрихи (или неподвижные).
· Тинкториальные свойства.
· Культуральные свойства.
Хорошо растёт на обычных питательных средах – колонии на агаре круглые, выпуклые, полупрозрачные. Рост на бульоне в виде диффузного помутнения. На всех дифференциально-диагностических средах E.coli, разлагающие лактозу, окрашены в цвет индикатора (на среде Эндо – тёмно-малиновые с металлическим блеском).
· Физиологические свойства.
Эшерихии – факультативные анаэробы, температурный оптимум для роста37 0 ,pH=7,2-7,5.
· Биохимические свойства.
Кишечная палочка в большинстве случаев способна ферментировать следующие углеводы с образованием кислоты и газа: глюкозу, лактозу, маннит, арабинозу, галактозу, иногда сахарозу. Образует индол, как правило, не образует H2S, восстанавливает нитраты в нитриты, не разжижает желатин, не растёт на голодной среде с цитратом, даёт положительную реакцию с MR и отрицательную – Фогеса-Проскауэра. По этим признакам её легко отличить от возбудителей ряда заболеваний, однако, патогенные E.coli ни по культуральным, ни по биохимическим свойствам очень часто не отличаются от непатогенных.
АГ классификация киш.палочки.
· Антигенные свойства.
У E.coli обнаружен 171 вариант О-антигенов, 57 вариантов Н-антигенов и 90 вариантов поверхностных К-антигенов. О-антиген означает принадлежность к определённой серогруппе, а Н-антиген – её серовариант. При более глубоком изучении были выявлены факторные О- и Н-антигены, т.е. их антигенные субварианты (Н2а, Н2b, H2c)
У Е. coli выделяют соматические (О-антиген), капсульные (К-антиген) и жгутиковые (Н-антиген) антигены.
В настоящее время известно около 170 антигенных вариантов Е. coli; более 80 из них вызывают коли-инфекцию. Диареегенные серовары кишечной палочки разделяют на 5 групп:
Классификация диареегенных Е. coli
·Энтеропатогенные Е. coli включают около 15 серогрупп и 29 сероваров.
·Энтероинвазивные Е. coli включают около 9 серогрупп и 13 сероваров. Наибольшее значение имеют штаммы 0124 и 0151.
·Энтеротоксигенные Е. coli включают 17 серогрупп и 16 сероваров.
·Энтерогеморрагические Е. coli включают серогруппы 0157, 026, 0111, 0145.
·Энтероадгезивные Е. coli окончательно не дифференцированы. Отличаются способностью быстро прикрепляться к кишечному эпителию.
Классификация диареегенной кишечной палочки.(то что в 5 вопросе, но вот табличка, в ней то же самое)
Качество, санитарно-гигиеническая оценка пищевых продуктов устанавливаются на основе комплекса органолептических, физико-химических и микробиологических показателей в соответствии с требованиями ГОСТов, Республиканских и Отраслевых стандартов и другой документации.
Известно, что патогенные микробы попадают во внешнюю среду (в том числе и на пищевые продукты) из организма больных (или бациллоносителей) людей и животных.
Непосредственное выявление патогенных микробов в естественных субстратах (воде, почве, пищевых продуктах) часто связано с большими затруднениями. Поэтому присутствие этих микроорганизмов устанавливают не прямым, а косвенным путем – по выявлению загрязнения исследуемых объектов выделениями человека и животных. Индикатором такого загрязнения объектов служит наличие на них санитарно-показательных микробов – возможных спутников болезнетворных микроорганизмов.
Санитарно-показательными микроорганизмами являются постоянные обитатели естественных полостей тела людей и животных. Вместе с выделениями организма они поступают во внешнюю среду и в течение определенного времени сохраняются в ней жизнеспособными. Поскольку вместе с ними будут (при наличии) выделяться и патогенные микробы, то обнаружение санитарно-показательных микроорганизмов, специфических для
данного выделения, косвенно указывает на возможное присутствие соответствующих патогенных микробов.
В отношении возбудителей кишечных инфекций (дизентерии, брюшного тифа, паратифа), естественно, роль таких индикаторов принадлежит представителям нормальной микрофлоры кишечника. Среди массы разнообразных микробов содержимого толстого отдела кишечника в очень больших количествах находятся кишечные палочки (сотни миллионов в 1 г) энтерококки, перфрингенс. Обнаружение этих бактерий в исследуемых объектах служит показателем их загрязнения кишечными выделениями (фекалиями) человека и свидетельствует о возможном наличии возбудителей кишечных заболеваний, которые выделяются из больного организма или бациллоносителя во внешнюю среду с фекалиями.
В настоящее время в качестве показателя фекального загрязнения объектов внешней среды (в том числе и пищевых продуктов) принята кишечная палочка. Эта бактерия была выделена впервые из испражнений человека Эшерихом (1885г.). Она является одним из представителей группы бактерий, сходных между собой по морфологическим и биологическим признакам. Всесторонние исследования этой группы бактерий были проведены И. Е. Минкевичем.
На основании неодинаковой способности использовать лимоннокислые соли в качестве источника углерода, способности сбраживать углеводы при повышенной температуре (43–45 °С) и некоторого различия в других биохимических свойствах бактерии группы кишечной палочки отнесены к трем родам семейства Enterobacteriaceae: к роду Escherichia – бактерии, типичные для кишечной микрофлоры человека и теплокровных животных; к родам Citrobacter и Enterobacter–бактерии, встречаемые тоже (особенно Citrobacter) в кишечнике, но чаще в природе (почве, на растениях). В связи с этим показательное значение бактерий этих трех родов в отношении фекального загрязнения объектов внешней среды будет неодинаковым. В ряде случаев в зависимости от целей исследования индикаторным организмом принимается лишь типичная фекальная кишечная палочка – Escherichia coli; в других – все представители группы кишечной палочки.
Экспериментальные исследования и наблюдения в естественных условиях показывают, что Е. coli под влиянием условий внешней среды способна значительно изменять биологические и ферментативные свойства и приобретать признаки цитробак-тера и энтеробактера. Поэтому при санитарных исследованиях чаще учитывают все бактерии группы кишечной палочки.
При санитарно-гигиенической характеристике пищевого продукта необходимо не только установить присутствие в нем кишечной палочки, но и учесть количество этих бактерий. Чем оно больше, тем вероятнее присутствие в объекте патогенных бактерий коли-тифозной группы. Поэтому определяют титр кишечной
палочки (коли-титр) и индекс кишечной палочки (коли-индекс). Под коли-титром понимают наименьшее количество (объем, масса) исследуемого материала, в котором обнаружена кишечная палочка. Коли-индексом называют число кишечных палочек в единице объема (массы) исследуемого материала.
Методы определения фекального загрязнения по обнаружению бактерий группы кишечной палочки и дифференциации отдельных представителей этой группы описаны в руководствах к лабораторным занятиям.
В настоящее время разработаны и введены в соответствующую документацию нормы допустимого содержания общей микробной обсемененности и кишечной палочки в питьевой воде и некоторых пищевых продуктах (см. гл. 6, 7).
Совершенствование нормирования пищевых продуктов по микробиологическим показателям обеспечивает безопасность продуктов в эпидемиологическом отношении, способствует повышению их качества и улучшению санитарного состояния предприятия.
Не нашли то, что искали? Воспользуйтесь поиском:
Группа компаний «Униконс»
Продвижение и реализация пищевых добавок, антисептиков и другой продукции НПО Альтернатива.
«Бесплатные образцы»
Комплексные пищевые добавки «Униконс».
Для всех отраслей пищевой промышленности!
«Петритест»
Микробиологические экспресс-тесты. Первые результаты уже через 4 часа.
- Вы здесь:
- Библиотека технолога
- Молочная промышленность
- Микробиология молока и молочных продуктов
5.3. БАКТЕРИИ ГРУППЫ КИШЕЧНЫХ ПАЛОЧЕК (БГКП) КАК ОСНОВНЫЕ САНИТАРНО-ПОКАЗАТЕЛЬНЫЕ МИКРООРГАНИЗМЫ
В группу БГКП входят представители нескольких родов семейства Enterobacteriaceae, в том числе Escherichia, Citrobacter, Enterobacter, Klebsiella, Serratia. Эти микроорганизмы обладают многими общими морфологическими, культуральными и биохимическими свойствами.
Бактерии группы кишечных палочек — короткие (длина 1-3 мкм, ширина 0,5-0,8 мкм) полиморфные подвижные и неподвижные грамотрицательные палочки, не образующие спор. Бактерии этой группы хорошо растут на простых питательных средах: мясопептонном бульоне (МПБ), мясопептонном агаре (МПА). На МПБ дают обильный рост при значительном помутнении среды; осадок небольшой, сероватого цвета, легкоразбивающийся. Образуют пристеночное кольцо, пленка на поверхности бульона обычно отсутствует. На МПА колонии прозрачные с серовато-голубым отливом, легко сливающиеся между собой. На среде Эндо образуют плоские красные колонии средней величины. Красные колонии могут быть с темным металлическим блеском (Е. coli) или без блеска (Е. aerogenes). Для лактозоотрицательных вариантов кишечной палочки (В. paracoli) характерны бесцветные колонии. Им свойственна широкая приспособительная изменчивость, в результате которой возникают разнообразные варианты, что усложняет их классификацию.
Большинство бактерий группы кишечных палочек (БГКП) не разжижают желатина, свертывают молоко, расщепляют пептоны с образованием аминов, аммиака, сероводорода, обладают высокой ферментативной активностью в отношении лактозы, глюкозы и других Сахаров, а также спиртов. Не обладают оксидазной активностью. По способности расщеплять лактозу при температуре 37°С БГКП делят на лактозоотрицательные и лактозоположительные кишечные палочки (ЛКП), или колиформные, которые нормируются по международным стандартам. Из группы ЛКП выделяются фекальные кишечные палочки (ФКП), способные ферментировать лактозу при температуре 44,5°С. К ним относится Е. coli, не растущая на цитратной среде.
На этих свойствах основано определение БГКП в молочных продуктах в средах Кесслер (в соответствии с 32901-2014 по образованию газа) или Кода (по изменению цвета индикатора) после термостатирования при температуре 37±1°С в течение 24 ч, а для мороженого — 48 ч. Дифференциально- диагностическая — среда Эндо, на которой Е. coli образует красные колонии с металлическим блеском. Образование полупрозрачных бесцветных или бледно-розовых колоний говорит о принадлежности микроорганизмов к лакгозоотри- цательным, в том числе патогенным энтеробактериям.
Санитарно-показательное значение родов неодинаково: наличие эшери хий свидетельствуют о свежем фекальном загрязнении, цитробактер и энтеробактер (иногда их считают измененными эшерихиями под влиянием пребывания во внешней среде) — показатели давнего или нефекального загрязнения.
В молоке БГКП хорошо размножаются, доводя его кислотность до 50- 80°Т и образуя в нем неровный ноздреватый сгусток. Молочнокислые микроорганизмы замедляют развитие БГКП. При режимах пастеризации, принятых в молочной промышленности, БГКП гибнут. Обычные дезинфицирующие средства полностью обеззараживают оборудование, инвентарь, руки от БГКП.
Дифференциацию БГКП можно проводить с помощью специальных тестов (комплекс признаков ТИМАЦ + Л):
Т — температурный тест (тест Эйкмана, выявляет способность эшери- хий ферментировать глюкозу, лактозу, маннит с образованием газа при 44- 45°С, другие не обладают такой способностью);
И- индолообразование (способность эшерихий расщеплять аминокислоту триптофан с выделением индола);
М — реакция с метиловым красным, заключается в определении кислотообразования при ферментации глюкозы: если индикатор изменяет светло-желтый цвет на красный, это свидетельствует о снижении рН до 5 и о наличии эшерихий и цитробактер, энтеробактер не изменяет цвет индикатора;
А- реакция на ацетилметилкарбинол (ацетоин), выявляет способность микроорганизмов образовывать это вещество в среде с глюкозой; проводится качественная реакция с гидроксидом калия и креатином, дающая розовый цвет, такой способностью обладают только представители рода цитробактер;
Ц — цитратный тест (способность микроорганизмов усваивать в качестве единственного источника углерода лимонную кислоту или ее соли, используют среду Козера с цитратами, цитробактер и энтеробактер растут на таких средах, называются цитратположительными бактериями, эшерихии — нет);
Л — лактозный тест (способность ферментировать лактозу).
Основные (наиболее стабильные) тесты — температурный и цитратный.
При воздействии факторов внешней среды (например, в присутствии антибиотиков) свойства БГКП могут меняться. Для дифференциации видов дополнительно определяют уреазную активность, рост на средах с цианистым калием, ферментацию различных углеводов, используют специальные таблицы.
Критерии санитарной оценки молочных продуктов и других объектов по присутствию СПМ предусмотрены действующими ГОСТ и СанПиН. Использовавшийся ранее показатель бродильного титра заменен показателем отсутствия БГКП в определенной массе продукта. Так, например, в пастеризованном молоке БГКП должны отсутствовать в 0,01 см, в ультрапастеризованном молоке — в 10 см 3 , ряженке — в 1 г, в кефирной закваске — в 3 мл, в твороге — в 0,001 г.
Индикатором кишечных инфекций является естественная микрофлора кишечника человека и теплокровных животных. Санитарно-показательными микробами могут служить постоянные обитатели кишечника человека, находящиеся там в большом количестве и обладающие определенными признаками, по которым облегчается их количественный учет.
Бактерии группы кишечной палочки.
В качестве показателя фекального загрязнения для воды еще в конце прошлого века предложено использовать бактерии группы кишечной палочки. За прошедшие сто лет в отношении воды предложены и другие санитарно-показательные организмы, но предпочтение отдается бактериям группы кишечной палочки как надежному показателю фекального загрязнения воды. Такое значение кишечная палочка приобрела по многим причинам. Прежде всего она преобладает среди микробного населения толстых кишок человека и теплокровных животных, содержится в фекалиях в огромном количестве — сотни миллионов в 1 г. Эти микробы устойчивы к внешним условиям и по выживаемости превосходят патогенную бактериальную микрофлору кишечника. Обнаружение в объектах среды кишечной палочки указывает на их фекальное загрязнение и возможное присутствие возбудителей желудочно-кишечных заболеваний.
Все многочисленные бактерии, входящие в группу бактерий кишечной палочки, имеют общие свойства: короткие аэробные или факультативно-анаэробные палочки, не образующие спор, окраска по Граму отрицательная, способны сбраживать глюкозу и другие сахара. На специальных средах растут в виде характерных колоний.
Бактерии группы кишечной палочки ведут себя идентично патогенным кишечным бактериям, поэтому они и сохраняют свое санитарно-показательное значение в качестве основного нормируемого показателя степени фекального загрязнения и одновременно косвенного индикатора эпидемиологической опасности водоемов для различного водопользования. Роль бактерий группы кишечной палочки отражается в официальных документах, и этот показатель нормируется.
Бактерии группы кишечной палочки являются основным критерием при оценке качества воды. Допустимо количество бактерий группы кишечной палочки в 1 л питьевой воды (коли-индекс): не более 3, в поверхностных источниках воды не более 10000.
Кишечная палочка или ее варианты являются индикаторами свежего фекального загрязнения. Другие виды колиформ могут расти или длительно сохраняться в средах фекального происхождения — они являются показателями старого фекального загрязнения, а также низкого санитарного состояния.
Загрязнение пищи палочкой Эшерихия коли указывает на возможность попадания в нее возбудителей желудочно-кишечных заболеваний. Поэтому роль коли-форм состоит в том, что они являются индикаторами загрязнения патогенными микробами.
Кишечные кокки и вирусы.
Во всем мире ведутся поиски новых индикаторных микроорганизмов. Кроме бактерий группы кишечной палочки предлагаются кишечные кокки (энтерококки), кишечные вирусы (энтеровирусы), фаги кишечной палочки и др.
Во многих странах энтерококки признаны дополнительным показателем загрязнения воды микробами фекального происхождения. Энтерококки обладают следующими характерными свойствами: имеют шаровидную форму, располагаются попарно, встречаются мелкие и крупные, а также различаются по форме — круглые, удлиненные, иногда сильно вытянутые. По Граму красятся положительно, каталазу не образуют. Энтерококки отличаются от других кокков, распространенных в окружающей среде, а также от тех, которые составляют нормальную микрофлору верхних дыхательных путей или патогенных для человека. Основное отличие — повышенная устойчивость к различным физическим и химическим факторам. Энтерококки очень быстро отмирают в летний период при повышенной температуре воды. Они являются естественными обитателями кишечника, их присутствие указывает на фекальное загрязнение окружающей среды. В окружающую среду энтерококки выделяются в меньших количествах и быстрее отмирают в воде и почве, чем кишечная палочка. Как правило, в этих объектах они не размножаются. Поэтому обнаружение энтерококков служит показателем свежего фекального загрязнения.
За рубежом энтерококки рассматриваются как наиболее надежные показатели фекального загрязнения воды закрытых источников, в частности колодцев.
Преимуществом энтерококков в качестве санитарно-показательных организмов является большая достоверность их фекального происхождения и отсутствие размножения в воде.
Наличие энтерококков подтверждает фекальное загрязнение воды в сомнительных случаях. Показано, что содержание в воде поверхностных источников кроме кишечной палочки энтерококков и фагов кишечной палочки в количестве более 1 тыс. в 1 л свидетельствует о недавнем поступлении фекального загрязнения, опасного в эпидемиологическом отношении.
Для оценки степени эпидемиологической опасности или степени вирусного загрязнения объекта, особенно при определении качества воды, возникла необходимость обнаружения вирусов кишечной труппы (энтеровирусов). Так как прямое определение вирусов сложно и длительно, стали искать санитарно-показательные организмы для оценки качества воды в отношении вирусного загрязнения. Такими микроорганизмами признаны фаги кишечной палочки (коли-фаги), которые в течение длительного времени выживают в воде, устойчивы к воздействию дезинфектантов.
Клостридии.
Некоторые бактерии рода Клостридиум, преимущественно Клостридиум перфрингенс, предложены в качестве санитарно-показательных микроорганизмов в отношении кишечных инфекций. Этот микроб обитает в кишечнике человека в довольно больших количествах и его можно быстро определить. Благодаря образованию спор рассматриваемые микроорганизмы длительно выживают в окружающей среде и очень устойчивы к внешним воздействиям. Присутствие их в воде расценивается как старое фекальное загрязнение. К действию хлора они чувствительны и при двукратном хлорировании воды на водопроводных станциях теряют термоустойчивость. Обнаружено, что одновременно с увеличением в воде количества санитарно-показательных клостридий увеличивается число возбудителей ботулизма, столбняка и газовой гангрены, особенно в отсутствие кислорода в процессе гниения и при благоприятной температуре. Это подтверждает индикаторное значение теста в отношении патогенных клостридий. Для оценки степени инфицирования объектов окружающей среды патогенными клостридиями они имеют первостепенное значение по сравнению с бактериями группы кишечной палочки, так как вызывают пищевые отравления, порчу консервов и т. п.
В используемой на консервных предприятиях воде количество клостридий нормируется: они должны отсутствовать в 100 мл. В ряде стран клостридии включены в стандарты качества воды как дополнительный показатель.
В группу санитарно-показательных клостридий объединяют грамположительные, образующие споры анаэробные палочки. Эта группа на 90-95 % состоит из Клостридиум перфрингенс и Клостридиум спорогенес. Санитарно-показательные клостридии служат показателем загрязненности объектов окружающей среды. Эти микробы более устойчивы, чем бактерии группы кишечной палочки, так как образуют споры. Это наиболее показательный тест в отношении патогенных и токсигенных клостридий.
Определение санитарно-показательных клостридий проводят в почве и питьевой воде, на пищевых предприятиях, при выборе новых источников водоснабжения.
Бактерии рода Escherichia является постоянными обитателями кишечника человека и животных и обнаружение их в воде, почве, на пищевых продуктах свидетельствует о фекальном загрязнении этих объектов. Это имеет большое санитарное и эпидемиологическое значение.
Бактерии родов Citrobacter и Enterobacter чаще обнаруживают в почве, на растениях, реже в кишечнике. Считают, что бактерии этих родов представляют собой результат изменения эшерихий после прибивание их во внешней среде. Следовательно, Citrobacter и Enterobacter являются показателями более давнего фекального заражения.
2. Санитарно-показательное значение энтерококков.
Энтерококки наряду с бактериями групп кишечных палочек являются постоянными обитателями кишечника человека и животных и в большом количестве выделяются во внешнюю среду.
Обнаружение их в почве, воде, пищевых продуктах свидетельствует о фекальном загрязнении этих объектов.
Обнаружение во внешней среде Str. faecalis — фекального стрептококка — является показателем загрязнения фекалиями человека, обнаружение Str. bovis и Str. equinus — показателем загрязнения фекалиями животных.
В международном и европейском стандарте по исследование питьевой воды энтерококк введен как дополнительный показатель фекального загрязнения воды.
Энтерококки как санитарно-показательные микроорганизмы имеют значительные преимущества перед бактериями группы кишечных палочек.
Они не подвергаются глубоким изменениям в объектах внешней среды.
Их легче идентифицировать, благодаря наличию питательных сред (среда Хайна, среда накопления Мак-Конки, среда Калины).
Они более устойчивы к воздействию физических и химических факторов. (например нагреванию, хлорированию и т.д.). Поэтому их используют при оценке качества хлорирования питьевой воды, при исследовании минеральных источников.
3. Санитарно — показательное значение сульфитредуцирующнх анаэробов.
Сульфитредуцирующие анаэробы обладают редуцирующими свойствами при росте на железосульфитных средах. Из всех многочисленных патогенных и сапрофитных видов рода Clostridium наиболее частым и постоянным обитателем кишечника человека и животных является Clostridium prefringens.
Этот микроб постоянно обитает в кишечнике человека и животных и выделяется в виде вегетативных форм, во внешней среде сохраняется в виде спор. Его соотношению обнаруженных в исследуемом объекте вегетативных форм микроба и количества спор судят о давности фекального загрязнения.
В качестве санитарно-показательного микроба CI. prefringens используют для контроля очистки сточных вод. Преимущество его перед Е. coli (кишечная палочка) состоит в том, что он не размножается в отстойниках.
При комплексной санитарной оценке почвы, воды открытых водоемов наряду с Е. coli, бактериофагом и энтерококком учитывают CI. perfiingens что позволяет определить давность фекального загрязнения исследуемых объектов.
4. Санитарно-показательпое значение бактерий рода Proteus. Микроорганизмы этой группы в небольшом количестве встречается как в кишечнике человека и животных, так и в окружающей среде, они являются возбудителями гнилостных процессов в природе.
Обнаружение больших количеств протея в почве, воде свидетельствует о содержании в них и разрушение органических веществ животного происхождения.
Бактерии рода протек применяют для санитарно-гигиенической оценки почвы, воды открытых водоемов. По наличию протея судят о качестве пищевых продуктов (мяса, колбасы, консервов). Обнаружение протея в пищевых продуктах свидетельствует о гнилостном процессе. Доброкачественные продукты не должны содержать бактерии рода Proteus.
5. Сапитарно — показательное значение бактериофагов. Бактериофаг представляет собой вирус бактерий, который размножается внутри бактериальной клетки и вызывая её лизис.
Бактериофаги встречаются там, где живут гомологичные им микробы. Они постоянно содержатся в кишечнике человека и животных, в объектах внешней среды, загрязненных фекалиями и навозом. Следовательно, кишечные бактериофаги это показатели фекального загрязнения почвы, воды энтеробактериями, в том числе патогенными.
Санитарно-показательное значение фагов возросло с водными вспышками вирусных заболеваний (полиомиелита, инфекционного гепатита и т.д.).
Установлено, что многие энтеровирусы и аденовирусы более стойки во внешней среде, чем кишечная, брюшнотифозная и дизентерийная палочки, т.е. в условиях, неблагоприятных для выживания энтеробактерий, ряд вирусов может сохранять жизнеспособность и представлять опасность для человека. Следовательно, по высокому коли-титру и низкому микробному числу, характеризующих безопасность воды в отношение возбудителей бактериальных кишечных инфекций, нельзя судить и о её безопасности в отношении возбудителей вирусных инфекций. В связи с этим в качестве индикаторов загрязнения воды патогенными энтеровирусами было предложено использовать фаги, которые по своим биологическим свойствам стоят к энтеровирусам ближе, чем любой другой санитарно-показательный микроорганизм.
Обнаружение кишечных бактериофагов в водоеме свидетельствует о фекальном загрязнении, опасном в отношении распространения вирусных инфекций,
Читайте также: